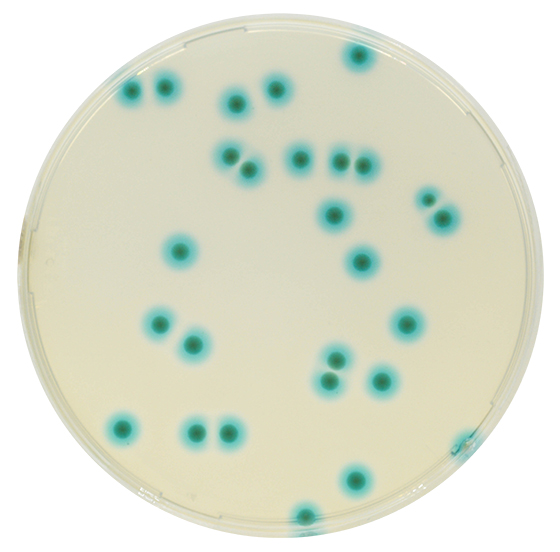

Über das Produkt
Chromogenes Medium zum qualitativen Direktnachweis, Differenzierung und präsumtiver Identifizierung von Bakterien des Burkholderia cepacia-Komplexes (BCC) bei Patienten mit zystischer Fibrose.
Ähnliche Produkte
CHROMagar™ B.cepacia (5L)